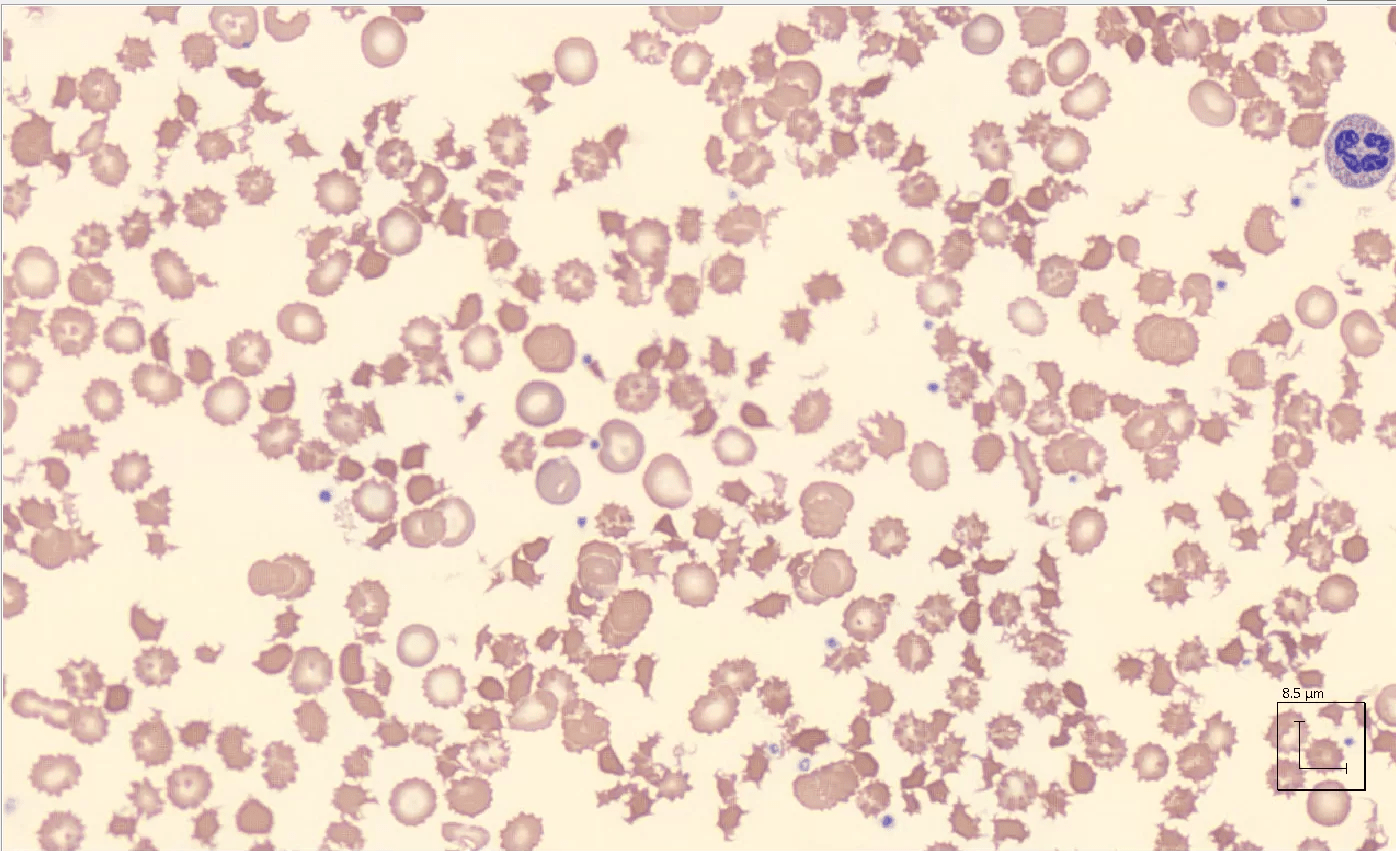

Peripheral smear of a patient with a history of prostate cancer and admitted with liver failure and signs of liver disease. His laboratory workup showed signs consistent with hemolysis and his smear seen above showed marked red blood cell abnormalities. Although the cells above could be similar to schistocytes, their shape is not consistent with a rupture of a red blood cell as it occurs in thrombotic microangiopathy. These red cells show spikes and shape more consistent with spur cells, typically seen in advanced liver disease.






